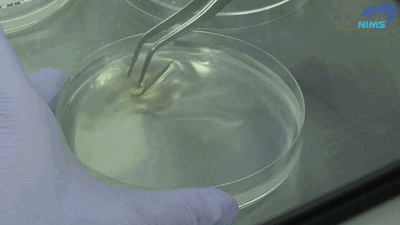
24

NIMS作为功能树脂材料方面专家

不断地推出各种各样的新材料
比如下面这种拨水涂层

又比如下面这种
可以防止贝类以及
海藻附在被涂装
物体表面的油漆

在赋予各种结构材料各种功能上
不断地推陈出新
这次要向大家着重介绍的
是纯天然原料制作而成的抗菌树脂

这次的新材料开发主角是
结构材料研究据点
非同种材质粘合材料小组的
内藤昌信先生

他这次盯上使用的
是在木材中含有的
多酚(polyphenol)的一种
叫丹宁酸(tannic acid)
它是造成柿子生涩

它除了具有抗菌作用外的特点

还比较便宜
如果能将此材料制作出涂料油漆
会有非常广泛的用途
再次介绍下这种新材料开发的
大背景
从目前的市场上看

为了赋予产品抗菌性能
主要是加入了银的纳米粒子

但在欧美为中心的市场
已经开始起草相关环保方面的法律
迫切需要开发可以取代银的材料
就是在这样的诉求下
内藤先生希望能开发出
以绿色天然材料为主原料的
新型抗菌材料
丹宁酸能非常轻易地
溶于水

把含有丹宁酸的水溶液
涂在金属或者玻璃上面
它跟这些材质之间的粘合性
是非常差的

躺在研究人员面前的一个重要问题
直接涂上丹宁酸的话
是不能形成表面均一的涂层的

而内藤所从事的研究
就是保持丹宁酸的抗菌特性的同时
还要赋予它成膜性能
他制作完成的改性丹宁酸

把这种特殊调配的溶液
跟上述实验中一样
涂在玻璃板上

这次形成了表面非常均一的树脂涂层

不单只是在玻璃上面
在金属以及塑料上面
都可以达到这种效果

在NIMS的纳米技术融合中心
进一步来检查该涂料的抗菌性

金黄色酿脓葡萄球菌
Staphylococcus aureus
把该细菌放入两个培养皿
然后在两个培养皿中
一个放入普通的PE薄膜

另一个则放入该丹宁酸薄膜

经过了一天之后的

把附在两个薄膜上面的细菌收集起来
移送到其他的培养皿
结果显示
涂在丹宁酸薄膜上的细菌
并没有增加
说明该改性丹宁酸的抗菌性
得到了保持
也说明该材料将可以应用在
多种材质上的广泛前景

除了这种涂覆成膜的丹宁酸
内藤先生还在维持丹宁酸
抗菌性能的同时
还开发的比如下面这种
喷雾用法的丹宁酸溶液

还有可以通过提升其胶黏性能
开发成具有抗菌性能的粘着剂

内藤先生介绍
他以及他们的研究团队可以
针对不同的用途
制作不同的型号的丹宁酸抗菌材料

可以做成上面所演示的喷雾剂
也可以做成胶黏剂
跟可以直接做成他手中拿的
(含)丹宁酸薄膜
并且能制作成不同的形状
这种(含)丹宁酸树脂

在比如智能手机的外壳部分等
个人电子产品上的应用领域
被寄予厚望
更多关于材料方面、材料腐蚀控制、材料科普等方面的国内外最新动态,我们网站会不断更新。希望大家一直关注中国腐蚀与防护网http://www.ecorr.org
责任编辑:王元
投稿联系:编辑部
电话:010-62313558-806
中国腐蚀与防护网官方 QQ群:140808414
免责声明:本网站所转载的文字、图片与视频资料版权归原创作者所有,如果涉及侵权,请第一时间联系本网删除。
官方微信
《中国腐蚀与防护网电子期刊》征订启事
- 投稿联系:编辑部
- 电话:010-62316606-806
- 邮箱:fsfhzy666@163.com
- 中国腐蚀与防护网官方QQ群:140808414



